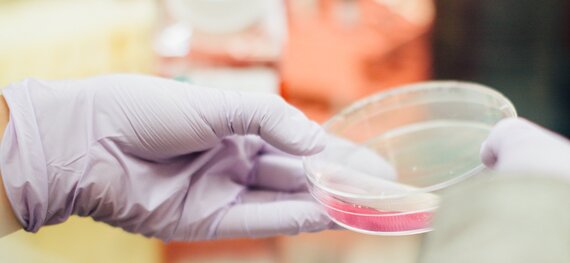

Forschungseinrichtungen am CCC-N
High-Tech Medizin für onkologische Spitzenforschung
Um Krebserkrankungen, ihre Ursachen und vor allem neue Behandlungsansätze zu erforschen, arbeiten am CCC-N Forschende beider Standorte Hand in Hand. Im CCC-N gibt es bereits eine langjährige, international ausgewiesene Expertise im Bereich Grundlagenforschung und translationaler Forschung. Diese soll es ermöglichen, Erkenntnisse aus der Grundlagenforschung in die klinische Anwendung zu übertragen.
Der Schwerpunkt der Forschungsaktivitäten am CCC-N spiegelt sich in unserem Leitmotiv „Präzision und Sorgfalt in Krebsforschung und -behandlung“ wider. Der Fokus liegt unter anderem auf der translationalen Forschung. Das CCC-N ist Teil der Allianz für Patientenbeteiligung in der Krebsforschung in Deutschland. Ziel der Allianz ist es, dass die Patientenbeteiligung in der Krebsforschung langfristig zu einem neuen Standard in Deutschland wird. Als CCC Niedersachsen gehören wir zu einer von über 60 Institutionen, die sich der Allianz angeschlossen haben.
CCC-N Forschungsprogramme
Die Forschungsaktivitäten am CCC-N sind in drei Forschungsprogramme unterteilt.
Forschungsprogramm 1: Genomdynamik und Immunregulation
Die Genomdynamik umfasst eine Vielzahl von kritischen Prozessen wie gestörte Replikation, Mitose, Epigenetik, Transkriptionskontrolle und DNA-Reparatur. Diese grundlegenden Mechanismen spielen eine entscheidende Rolle bei der Tumorprogression, der therapeutischen Reaktion und der Entstehung von Resistenzen. Darüber hinaus kann die Genomdynamik die Immunregulation durch Faktoren wie DNA-Schäden und verschiedene epigenetische Pfade beeinflussen. Unser Ziel ist es, beides - die Genomdynamik und die Immunregulation - ganzheitlich zu verstehen, um neuartige Therapien wirksam anpassen zu können.
Forschungsprogramm 2: Stratifikationsbasierte Therapie
Die stratifikationsbasiertesbasierte Krebstherapie ist ein Behandlungsansatz, bei dem die Maßnahmen auf die einzigartigen Merkmale der einzelnen Patient*innen und ihrer Tumorerkrankungen zugeschnitten werden. Dieser Ansatz maximiert die Wirksamkeit der Behandlung und minimiert gleichzeitig mögliche Nebenwirkungen. Das Programm zur stratifikationsbasierten Therapie umfasst die Entwicklung von Biomarkern unter Verwendung großer Patientenkohorten und Biobankmaterialien, wobei der Schwerpunkt auf klinischen Registern und Biomaterialproben durch die Niedersächsische Einheitliche Biobank (LSUB) liegt. Der Ansatz zielt darauf ab, Patientenuntergruppen für gezielte klinische Studien zu identifizieren, bei denen auch Datenwissenschaft und Bildgebungstechnologien eingesetzt werden.
Forschungsprogramm 3: Prävention und Versorgungsforschung
Das Programm zur Krebsprävention und Versorgungsforschung des CCC-N umfasst die Früherkennung, die Behandlung von Krebsvorstufen sowie die Ergebnis- und Umsetzungsbewertung, einschließlich psychosozialer, palliativer und unterstützender Betreuung. Es werden u.a. Bildgebungs-, Pathologie- und Genomsequenzierungsdaten, große Register sowie sozialmedizinische und epidemiologische Methoden genutzt, um die Patientenversorgung zu untersuchen und zu optimieren.
CCC-N Forschungsprojekte

Kontaktinformationen
- E-Mail-Adresse: guenter.schneider(at)med.uni-goettingen.de

Kontaktinformationen
- E-Mail-Adresse: E-Mail-Adresse: saborowski.anna@mh-hannover.de
Medizinische Hochschule Hannover
Klinik für Gastroenterologie, Hepatologie, Infektiologie und Endokrinologie
Leitung des Zentrums Personalisierte Medizin im CCC Hannover